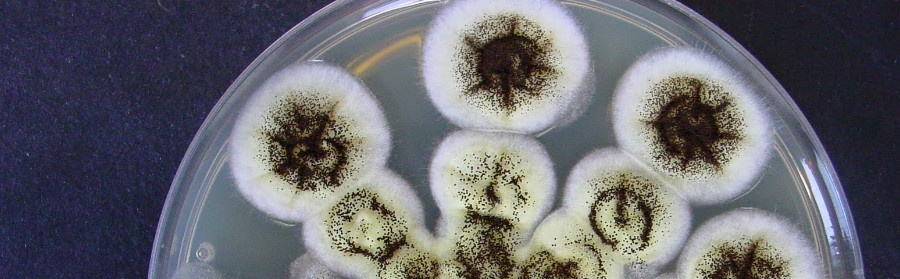

mostbet ios yuklab olish [url=www.mostbet3037.ru]www.mostbet3037.ru[/url] .
A proposito de un caso...
CASO 1:

Neumonia por Klebsiella pneumoniae....
mostbet_zbmt
Fecha: 04.06.2025 | Autor: mostbet_fbmt
1win_bbpt
Fecha: 04.06.2025 | Autor: 1win_bbpt
1вин мобильное приложение уз [url=www.1win14012.ru]www.1win14012.ru[/url] .
купить 1с в москве
Fecha: 04.06.2025 | Autor: kypit 1s v moskve_hymi
программа 1с стоимость [url=erp-sistema-1s.mystrikingly.com]программа 1с стоимость [/url] .
1win_muSi
Fecha: 04.06.2025 | Autor: 1win_ptSi
авиатор игра на деньги [url=1win22088.ru]1win22088.ru[/url] .
Купить айфон
Fecha: 03.06.2025 | Autor: Kypit aifon_ocsr
где купить айфон в питере [url=www.kupit-ajfon-cs12.ru]где купить айфон в питере[/url] .
1win_jxmi
Fecha: 03.06.2025 | Autor: 1win_kbmi
1win texnik yordam [url=1win14011.ru]1win14011.ru[/url] .
магазин сантехники в донецке
Fecha: 03.06.2025 | Autor: magazin santehniki v donecke_onSt
сантехника донецк днр [url=santehnika-doneck-1.ru]santehnika-doneck-1.ru[/url] .
1win_wbKl
Fecha: 03.06.2025 | Autor: 1win_zsKl
1win app yuklash uz [url=www.1win3006.ru]www.1win3006.ru[/url] .
Купить айфон
Fecha: 02.06.2025 | Autor: Kypit aifon_ahml
regbnm fqajy cg, [url=www.kupit-ajfon-cs13.ru/]regbnm fqajy cg,[/url] .
Приобрести диплом ВУЗа!
Fecha: 02.06.2025 | Autor: Trefqpq
купить диплом [url=www.diplom-groupm.online]www.diplom-groupm.online[/url] .
Caso 2: MICETOMA EN DBT
https://www.scielo.org.ar/scielo.php?script=sci_arttext&pid=S1851-300X2009000100001